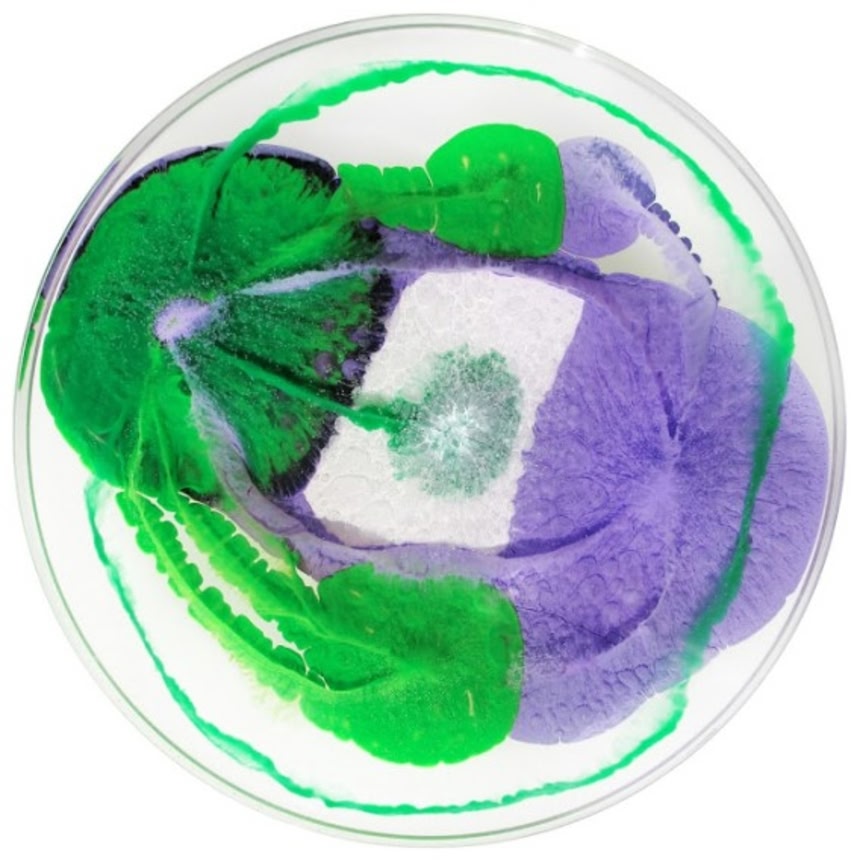
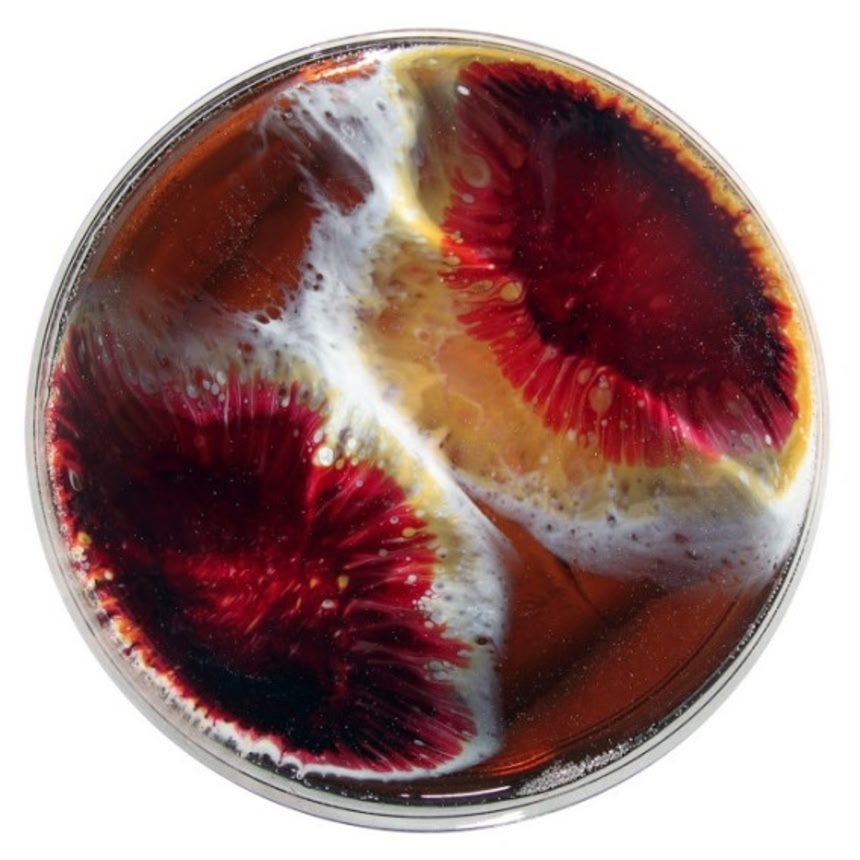
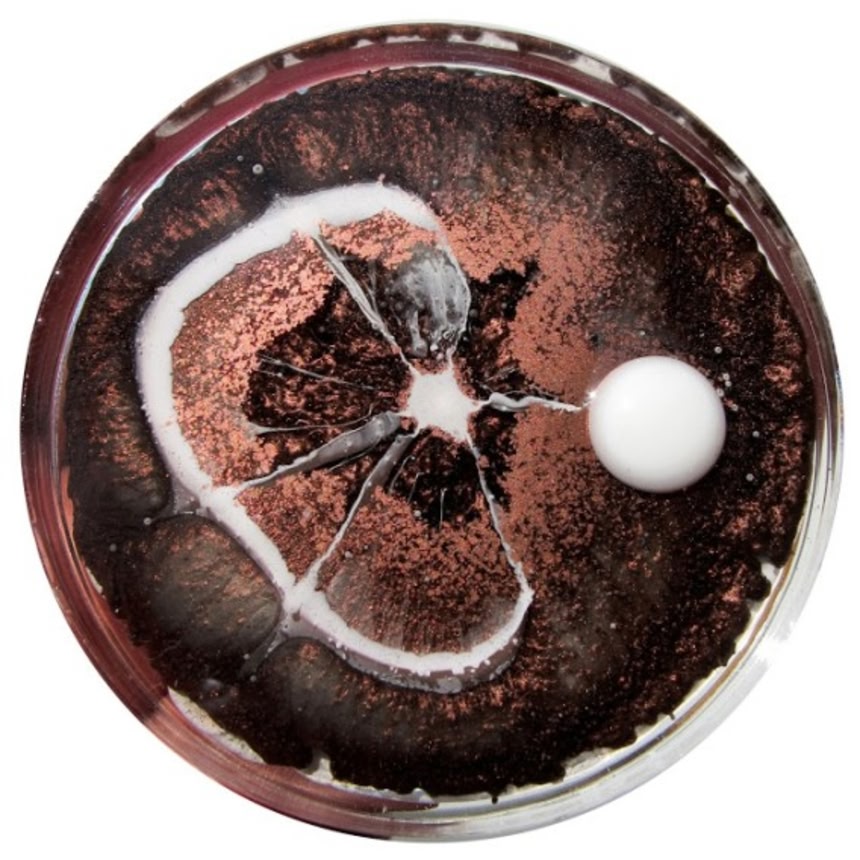

この画像を大きなサイズで見る
この画像を大きなサイズで見るAdvertisement
ペトリ皿(シャーレ)に様々な色の絵の具を乗せて、そこに小宇宙を表現。これを毎日繰り返して行っているという、米サンフランシスコ在住のアーティスト、クラリ・レイスさん。
一応テーマが設定されていて「現代のバイオテクノロジーと私たちの日々の複雑な関係を探る。」ということらしい。科学とアートは時に融合し、見たこともない芸術作品を作り出す。意図してなかった科学技術の最終形態がアートみたいだったというのが一般的な流れだが、逆に芸術家の方が科学にアプローチを仕掛けたみたいな感じになっている。
■1.
 この画像を大きなサイズで見る
この画像を大きなサイズで見る■2.
 この画像を大きなサイズで見る
この画像を大きなサイズで見る■3.
 この画像を大きなサイズで見る
この画像を大きなサイズで見る■4.
 この画像を大きなサイズで見る
この画像を大きなサイズで見る■5.
 この画像を大きなサイズで見る
この画像を大きなサイズで見る■6.
 この画像を大きなサイズで見る
この画像を大きなサイズで見る■7.
この画像を大きなサイズで見る
この画像を大きなサイズで見る■8.
 この画像を大きなサイズで見る
この画像を大きなサイズで見る■9.
 この画像を大きなサイズで見る
この画像を大きなサイズで見る■10.
 この画像を大きなサイズで見る
この画像を大きなサイズで見る■11.
 この画像を大きなサイズで見る
この画像を大きなサイズで見る■12.
 この画像を大きなサイズで見る
この画像を大きなサイズで見る■13.
この画像を大きなサイズで見る
この画像を大きなサイズで見る■14.
 この画像を大きなサイズで見る
この画像を大きなサイズで見る■15.
 この画像を大きなサイズで見る
この画像を大きなサイズで見る■16.
この画像を大きなサイズで見る
この画像を大きなサイズで見る■17.
 この画像を大きなサイズで見る
この画像を大きなサイズで見る■18.
 この画像を大きなサイズで見る
この画像を大きなサイズで見る■19.
 この画像を大きなサイズで見る
この画像を大きなサイズで見る■20.
 この画像を大きなサイズで見る
この画像を大きなサイズで見る■21.
 この画像を大きなサイズで見る
この画像を大きなサイズで見る■22.
 この画像を大きなサイズで見る
この画像を大きなサイズで見る理科の実験室にあるようなビーカーとかシャーレとかリトマス紙とかアラジンと魔法のランプとか、そんなものが自宅にあるってだけで心が躍ってしまうのはあたしだけだろうか?
📌 広告の下にスタッフ厳選「あわせて読みたい」を掲載中
















いや、一度カビに見えてしまうと、もうカビにしか見えない…
純粋にすごいわ
19が一番中二心くすぐる
深淵に呑まれ潜血に染まる光って感じw
12番綺麗ですなあw
有害でキタナイものにしか見えない…
菱沼さんがうらやましがりそう
臓器とかそっち系のグロ画像に見える
「この培地もう駄目だなぁ」と思ってしまう
最初カビだと思っていたときは汚いと思っていたが絵具と判ってみていたら綺麗に見えてきた。
俺って結構いい加減だな。
あとジャボチンスキー反応を思い出した。
綺麗だけど、鼻を刺す刺激臭とかするんだろうな…
洗うの嫌だなーでも放っておいちゃダメだよなー
黴菌が肺に入ったらどうしよう。 って思ってしまう
絵の具を水面から紙に転写させるやつなんていったっけ?思い出せない
なんかグロい…
>>12
マーブリングだったかな。
20が綺麗
うちわのデザインっぽい